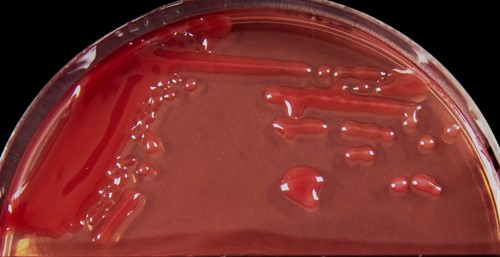

Rhizobiaceae
Esta familia pertenece al orden Rhizobiales y cuenta con 14 géneros descritos (Taxonomy Browser-NCBI). Los miembros de esta familia se encuentran libres en el suelo o formando simbiosis con algunas plantas. Las bacterias son fenotípicamente heterogéneas, predominantemente aerobias, y presentan una morfología bacilar Gram negativa. Muchas especies presentan plásmidos grandes que albergan una gran parte del genoma, e incluyen genes relacionados con la especificidad de su hospedero. Algunos miembros se caracterizan por su habilidad de establecer asociaciones simbióticas con hospederos específicos y desarrollan procesos de fijación biológica de nitrógeno. Otros géneros son patógenos para las plantas. En esta familia se encuentran los géneros Rhizobium y Ensifer, los cuales son ampliamente utilizados en la agricultura (Carareto Alves et al., 2014).